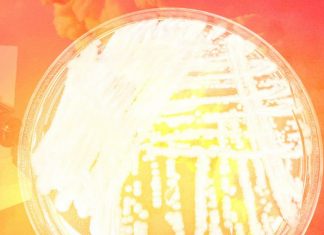
Meet the deadly new fungus (possibly) brought to you by climate change – Grist

Saturday’s Trending 3 – WCAX
Saturday's Trending 3 WCAXBURLINGTON, Vt. There is a Work Zone Safety Rally happening today in Montpelier. It was a tragic story when flagger James Alger was hit and killed on the job ...
Drone Sensor Market 2019-2026: New Trending Research Analysis – NewsStoner
Drone Sensor Market 2019-2026: New Trending Research Analysis NewsStonerGlobal Drone Sensor Market was valued at USD 269 Million in 2017 and is projected to reach USD 1.2 Billion by 2025, growing at a CAGR of...
Military Photos Delta IV Launch – Strategy Page
Military Photos Delta IV Launch Strategy PageUnited Launch Alliance's Delta IV rocket takes off for final flight CNETThe last single-stick Delta rocket launched Thursday, and it put on a show Ars TechnicaDelta IV Medium Rocket, the Last...
Morehouse announces plans for how student loan debts will be paid off – Atlanta...
Morehouse announces plans for how student loan debts will be paid off Atlanta Journal ConstitutionBillionaire Robert F. Smith's $34 million gift to Morehouse grads includes parent loans USA TODAYRobert F. Smith pledges to pay off Morehouse...
What Josh Gordon’s return to Patriots means in the short term, long term –...
What Josh Gordon's return to Patriots means in the short term, long term WEEIPats players 'pulling for' reinstated WR Gordon ESPNBill Belichick offers cryptic statement on Josh Gordon's reinstatement Yahoo SportsBill Belichick is in midseason halftime interview...
Second West Nile Virus found this summer in Reno – KOLO
Second West Nile Virus found this summer in Reno KOLOAdams County Confirms Mosquito Infected With West Nile Virus CBS Denver7 dead in Maricopa County due to West Nile virus, officials say AZFamilyWest Nile Virus still a concern...
Woman arrested after buying AK-47, threatening old school – Knoe.com
Woman arrested after buying AK-47, threatening old school Knoe.comWoman accused of making terroristic threats against school CNNOklahoma woman, 18, threatened to 'shoot 400 people for fun' at former high school, officials say Fox NewsAffidavit: Former student referenced...
So It Turns Out Hackers Can Steal Yr Data Using An App That’s Pre-Installed...
So It Turns Out Hackers Can Steal Yr Data Using An App That's Pre-Installed On All iPhones Pedestrian TVWarning Issued For Apple's 1.4 Billion iPad And iPhone Users ForbesYour iPhone contacts list could be a vulnerable...
Global Wall Mounted Gas Boiler Market 2019 Trending Technology – BOSCH, Vaillant, Squirrel ,...
Global Wall Mounted Gas Boiler Market 2019 Trending Technology – BOSCH, Vaillant, Squirrel , Viessmann, Vanward Market Research TimeMarketandResearch.biz announced that it's published an exclusive report namely Global Wall Mounted Gas Boiler Market 2019 by...
Woman who lied about spreading HIV charged with misdemeanor – WRDW-TV
Woman who lied about spreading HIV charged with misdemeanor WRDW-TVGeorgia woman who claimed to use HIV for revenge doesn't have the STD New York Post Americus woman tests negative for HIV after Facebook video goes viral WALBWoman...
Florida officials say they ‘dodged a missile’ as Hurricane Dorian moves north – NBCNews.com
Florida officials say they 'dodged a missile' as Hurricane Dorian moves north NBCNews.comHurricane Dorian's eye now east of Daytona Beach, Granada Bridge reopens Daytona Beach News-JournalMandatory curfew issued for Volusia County ABC Action NewsLIVE UPDATES: 20 reported...
New Jersey deck collapse injures at least 22 people, officials say – msnNOW
New Jersey deck collapse injures at least 22 people, officials say msnNOWDeck collapse in New Jersey injures 22 people ABC News22 Injured After Decks Collapse During New Jersey Firefighters' Event BreitbartOfficials: Pancake Collapse Took Down Wildwood Deck CBS...
Chicago-area kindergarten teacher charged in sexual assault – WREX-TV
Chicago-area kindergarten teacher charged in sexual assault WREX-TVBaptist schoolteacher who is pastor’s wife traded alcohol for sex with minor student, sent nude images, prosec Chicago TribuneBond set at 750K for Burbank teacher charged with sexual assault WGN...
On the front line of the Ebola epidemic – Aljazeera.com
On the front line of the Ebola epidemic Aljazeera.comThe slow burn of Congo’s Ebola outbreak demands a redefinition of ‘America First’ The Washington PostAn Ebola Doctor Explains the Good News and Bad News of the New...
Global Aviation Turbine Fuel Market Trending Research Report 2019 – Air BP, Chevron, Exide,...
Global Aviation Turbine Fuel Market Trending Research Report 2019 – Air BP, Chevron, Exide, Exxon Mobil, Gazprom Market Research TribuneGlobal Aviation Turbine Fuel Market Overview: Our latest research report documents details about Global Aviation Turbine...
Meet the deadly new fungus (possibly) brought to you by climate change – Grist
Meet the deadly new fungus (possibly) brought to you by climate change GristDeadly new fungal superbug is worrying doctors — here's what you need to know Yahoo LifestyleClimate change may lead to more fungal infections, study...
Kmart stores set to dwindle to 1 in Mountain State – WV MetroNews –...
Kmart stores set to dwindle to 1 in Mountain State - WV MetroNews West Virginia MetroNewsKmart, Sears closing additional stores by the end of the year. Is your location closing? USA TODAYLast Kmart store in Syracuse...
Joe Biden Recalls Terrifying 1960s Public Pool Confrontation With Razor-Wielding Gangster Named “Corn Pop”...
Joe Biden Recalls Terrifying 1960s Public Pool Confrontation With Razor-Wielding Gangster Named "Corn Pop" RealClearPoliticsBiden, in resurfaced 2017 clip, recounts bizarre razor-and-chain showdown with 'bad dude' gang leader Corn Pop Fox NewsTwitter Mocks Joe Biden Over...
Temperatures trending down into weekend – 41 NBC News
Temperatures trending down into weekend 41 NBC NewsMACON, Georgia. (41NBC/WMGT) – We set a new record high temperature of 98° at the Middle Georgia Regional Airport yesterday, but “less hot” temperatures ...
Global Mdium DMEM Market Trending Research Report 2019 – Thermo Fisher Scientific, Lonza, Miltenyi...
Global Mdium DMEM Market Trending Research Report 2019 – Thermo Fisher Scientific, Lonza, Miltenyi Biotec, Mediatech Market Research TribuneGlobal Mdium DMEM Market Overview: Global Mdium DMEM Market Growth 2019-2024 is the decisive study of the...